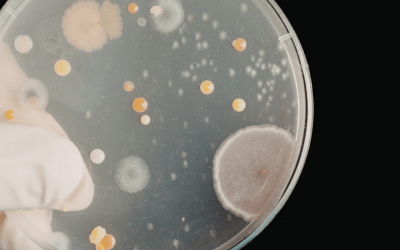
Yeast Overgrowth: Could Candida Be Running the Show in Your Gut?

Heal Your Gut
- Enjoy Your Food
- Feel Amazing
- Enjoy Your Food
- Feel Amazing
Heal your gut
FEEL AMAZING
Enjoy your food
Free Mini Programme
Would You Like to Learn How to Fix Your Digestive Symptoms, Beat the Bloat and Feel Amazing?
1:1 Coaching Plans
Get Ready to Permanently Beat the Bloat, Soothe Your Digestion and Feel Amazing
Ultimate Gut Health Programme
Delicious, Filling & Inspiring ways to Become Symptom-Free, Soothe Your Gut and Enjoy Your Food Again!
Hello! I’m Liz
Women’s Nutritionist and Gut Health Specialist
I’m a fully qualified Nutritional Therapist who has spent years studying nutritional science and working with clients to help them reach their health goals and soothe their gut symptoms.
I’ve experienced my own personal battle with candida – a journey which inspired me to train to become a nutritional therapist so I could help others heal their digestive symptoms, safely and permanently.
I fully understand how vital gut health is – gut health isn’t just confined to the gut – it impacts your mental health, outlook on life, energy levels, weight, immunity and much, much more.
Watch the video below to hear about my journey or if you prefer you can read more about me.
How I work
Effective treatment of ongoing digestive distress requires a holistic approach which discovers the triggers for your symptoms and addresses them from the ground up, it is not simply the management of symptoms.
I have developed a signature system which brings into balance all the areas where there may be underlying imbalances affecting your digestive system, imagine a life where…
- You can enjoy your food again without constantly worrying about ‘trigger foods‘ which result in bloating, cramping and other digestive symptoms.
- You look and feel totally amazing: Confident, Full of Energy, Glowing Skin, Slim and Happy.
- Career, study, days out with family and friends – whatever you need to do its a breeze! Your days of relying on antacids and laxatives to get your through the day are far behind you.
(YES! All this is really possible even if you’ve been battling for years with ‘IBS’ symptoms and you’re exhausted by researching on Dr Google for information!
1. Discover
2. Nourish
3. Renew
4. Balance
Free Mini Programme
Would You Like to Learn How to Fix Your Digestive Symptoms, Beat the Bloat and Feel Amazing?
1:1 Coaching Plans
Get Ready to Permanently Beat the Bloat, Soothe Your Digestion and Feel Amazing
Ultimate Gut Health Programme
Delicious, Filling & Inspiring ways to Become Symptom-Free, Soothe Your Gut and Enjoy Your Food Again!
Happy Clients
Video from Elaine
I suffered from bad anxiety which I had medication for. I felt my emotions in my tummy which would result in IBS symptoms – I always had an emotional tummy.
Certain foods gave me bloating, especially dairy (which made me feel sick too) and pasta, and I ended up in hospital for tests as things had gotten so bad.
That’s when I decided to see Liz, she made a few simple tweaks to my diet and literally within days I started to feel better – “I’m so glad I came to see you”Lara
“Sometimes when I ate bread and those types of foods I’d get very bloated and need to go to the loo very urgently. This really got in the way when I was on days out.
Now, only a few weeks into my program, I feel great! My clothes are looser, I’ve got no bloating and loads of energy. In fact, I completely do not feel tired any more – even when my daughter wakes at 2am!”Suzanne
The Blog...
Zinc & Gut Health: Are You Affected by a Hidden Deficiency?
(Hint: If you’ve got gut problems, you might be low in zinc.) Zinc is one of those quiet powerhouse nutrients that doesn’t get much attention — until something starts going wrong. From immune defence to gut integrity, zinc plays a central role in keeping your body...
Yeast Overgrowth: Could Candida Be Running the Show in Your Gut?
“Having candida” is one of those phrases that gets thrown around a lot — often without much context. Here’s the truth: candida albicans is a normal and necessary part of your gut flora. It should always be there… just quietly minding its own business in small amounts....
Low Iron Levels: Signs You’re Deficient (and How to Boost Absorption Naturally)
Low iron levels are far more common than most people realise — especially if you’re female and pre-menopausal, vegetarian or vegan, or living with digestive issues. Iron deficiency often flies under the radar, yet it can have a huge impact on your energy, hormones,...